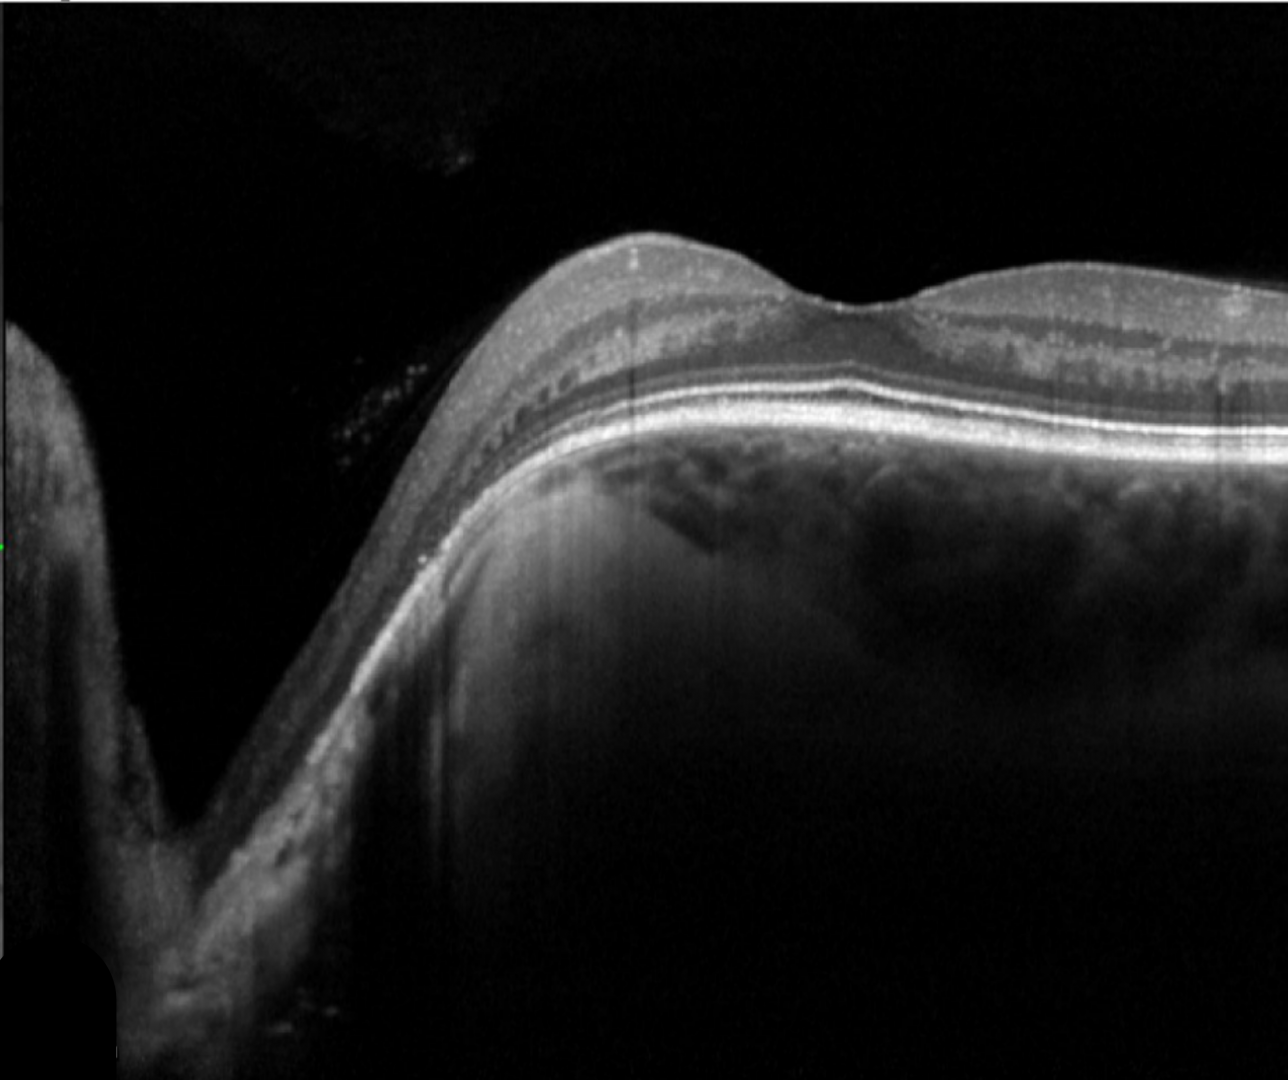

Overview
Congenital optic disc pits are small, hypo-pigmented grayish oval or round excavations in the optic nerve head which can be bilateral in 10-15% of cases. Whilst typically seen temporally on the disc, they can be found at any location either centrally or at the edge of the disc.
Acquired pits may be associated with high myopia or glaucoma but in the absence of either of these two conditions, an optic disc pit is most likely to be congenital.
Optic disc pits can be associated with a serous detachment of the retina, intraretinal fluid or schisis – termed optic disc pit maculopathy. Maculopathy will typically occur in the third to fourth decade of life and can be associated with a reduction in visual acuity. While spontaneous regression can occur, most cases have a poor prognosis with a gradual worsening of vision. The literature varies in estimating the prevalence of maculopathy but it is reported to be in the range of 25-75% of patients with optic disc pits.
Case Examples
-
Case 1: Optic disc pit
A 61 year old asymptomatic Caucasian female with best corrected visual acuity of 6/6 (20/20) in the right eye.
-
Case 2: Optic disc pit
A 25 year old Caucasian female with enlargement of the blind spot in the left eye on visual field testing. Her vision was 6/6 (20/20) in each eye and the right eye was unremarkable so this case will concentrate on the left eye only.
-
Case 3: Optic disc pit maculopathy
A 57 year old asymptomatic Asian female with best corrected visual acuity of 6/6 (20/20) in each eye.
Differential diagnosis
References
Chatziralli, I., Theodossiadis, P., & Theodossiadis, G. P. (2018). Optic disk pit maculopathy: current management strategies. Clinical ophthalmology (Auckland, N.Z.), 12, 1417–1422.
Kyoko Ohno-Matsui, Akito Hirakata, Makoto Inoue, Masahiro Akiba, Tatsuro Ishibashi; (2013) Evaluation of Congenital Optic Disc Pits and Optic Disc Colobomas by Swept-Source Optical Coherence Tomography.
Moisseiev, E., Moisseiev, J. & Loewenstein, A. (2015) Optic disc pit maculopathy: when and how to treat? A review of the pathogenesis and treatment options. Int J Retin Vitr 1, 13.


